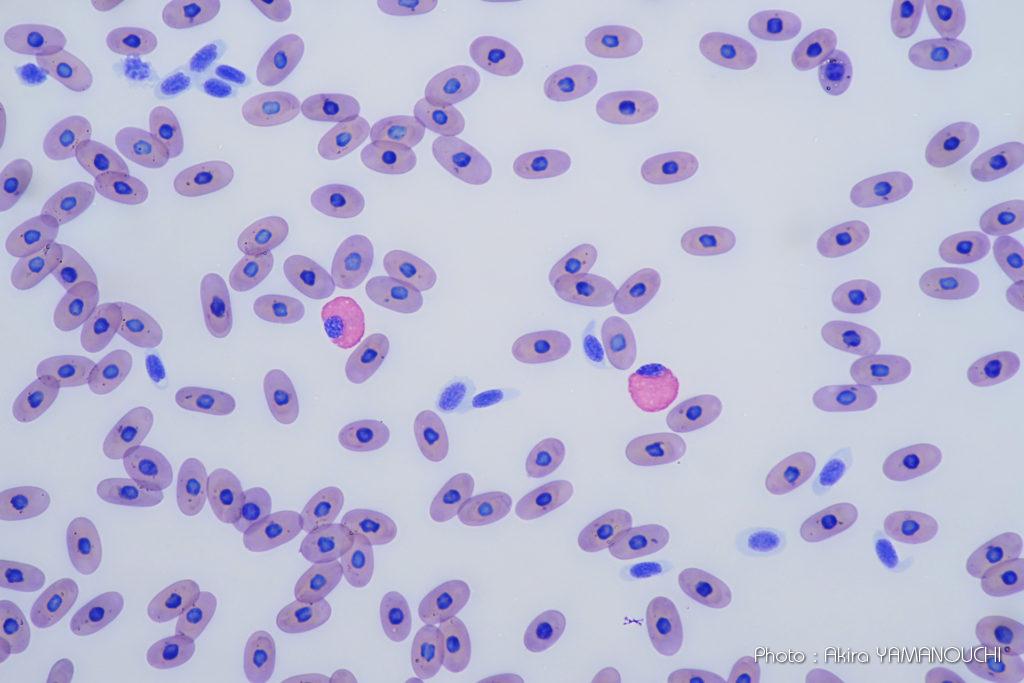
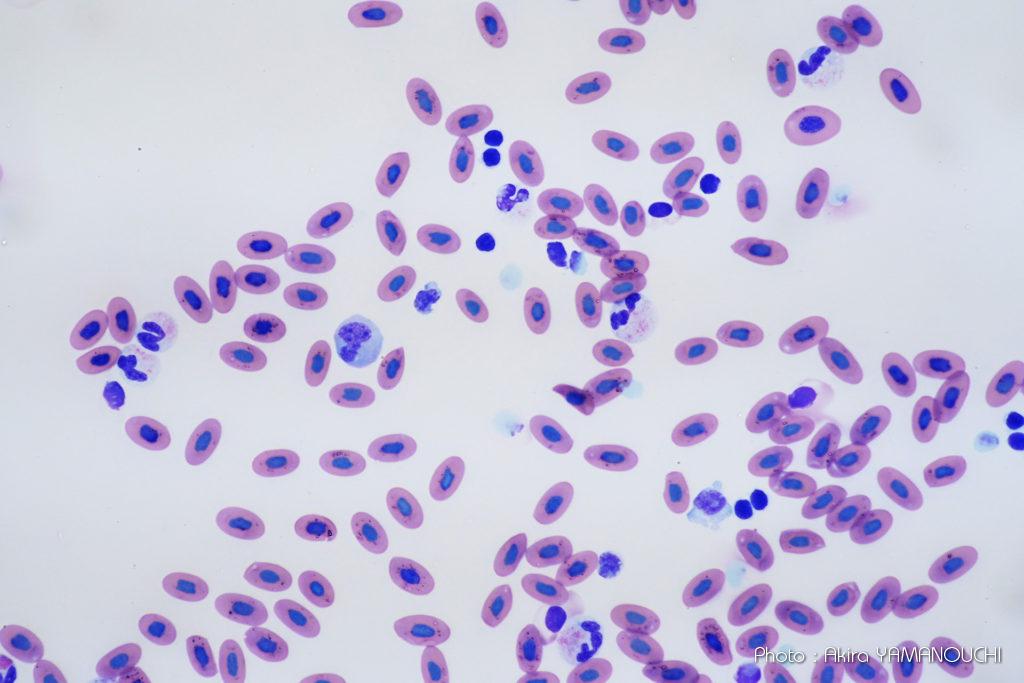
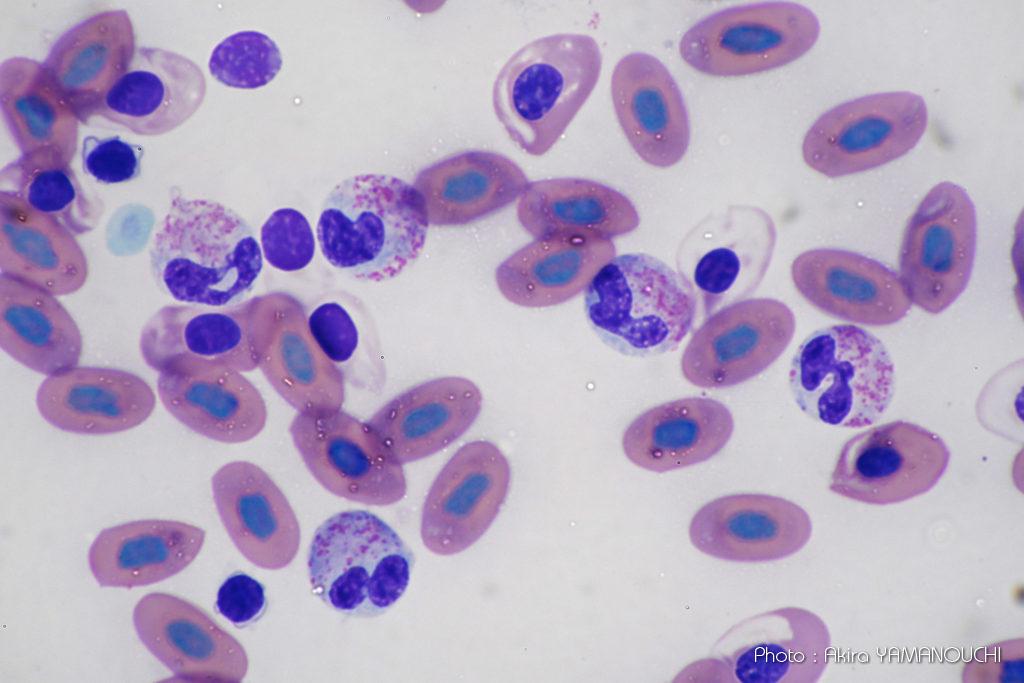

顕微鏡画像撮影も仕事としています。フィルム時代からなので、かれこれ30年以上生業としていますが、デジタル時代になってからはいち早くデジタルカメラを導入して使用しています。
とは言っても顕微鏡写真の依頼は日々来るものではなく、せいぜい月一程度です。そのために顕微鏡専用のカメラを買うまでもないので、一眼レフ時代は普段普通の撮影業務で使っていたD1x、D2xs、D300s、D500と使ってきました。
一眼レフなので、ファインダー像を見るためにアングルファインダーを装着したり、ミラーブレ・シャッターブレを防ぐために遅延露出をする必要がありますが、きちんと調整を行えばセンサーの大きさを活かして顕微鏡専用のカメラにも勝るとも劣らない画像を撮ることができます。当時の顕微鏡専用カメラは小型CCDのカメラで、誰でも気軽に撮れる半面、あまり画質が良いものではありませんでした。
一眼レフで撮影した写真の方が諧調が豊で回折ボケも少なく、専用カメラよりも情報量が多かったのです。当時は正しい顕微鏡写真が撮れる人は少なく、学会発表や論文用として、血球や組織像の撮影の需要が結構ありました。
ミラーレス時代
ミラーレス時代になってからは状況が一変します。ミラーレスの機構は顕微鏡カメラとしては最適です。中でも電子シャッターのみで撮影できるミラーレスカメラの出現によって、顕微鏡写真の分野では、フィルムカメラはもちろんのこと、デジタル一眼レフ、コンパクトカメラ、顕微鏡専用カメラが淘汰されてしまいました。
電子シャッターのミラーレス一眼は、あらゆる面で今までの顕微鏡撮影システムを凌駕しています。
ファインダー
センサーの像がリアルタイムにそのまま見えるので、EVFでも液晶モニターでも撮影できます。顕微鏡撮影では、三眼鏡筒を使い、上部にカメラを下に向けて取り付けるため、液晶モニターを開いて使うと便利でしょう。構図、ピント、露出などをすべて液晶モニターで確認できます。
カラーバランス
明視野照明の背景は無彩色でないといけません。実際は照明の光量などによって色温度がかなり変わります。フィルム時代はフィルターワークで調整していましたが、デジタルになってからはホワイトバランスが調整できるようになりました。今では当たり前ですがデジタルカメラの恩恵です。もちろん、ミラーレス一眼でもホワイトバランス調整は可能なので、撮影前に背景が無彩色になるように調整します。
露出
顕微鏡撮影で一番難しかったのは露出ではないでしょうか。デジタルよりもフィルムの方がラチチュードが広く、かえって楽だったかもしれません。デジタル時代になって露出はシビアになりましたが、それでも撮影後にすぐ確認できるため、失敗は劇的に少なくなったことでしょう。
ミラーレスになってからは、露出も含めて撮影後の姿が撮影前から見えているので、露出に関しては失敗はなくなりました。これはミラーレスの大きな恩恵です。
ブレ
フィルム時代やデジタルになってからもミラーやシャッターがある以上、常にブレとの闘いがありました。微細なものの撮影ですから、少しの振動でもそれが拡大されて大きなブレとなります。特に一眼レフはミラーの振動が大きかったため、露出ディレー(ミラーを跳ね上げてから数秒時間をおいて、振動が収まってからシャッターを開く機構)を使う必要がありました。
大きなミラーブレは防げますが、ミラーの質量に比べて小さいシャッターでも顕微鏡撮影ではブレを発生させるため、完全にブレを消去することはできませんでした。
シャッターブレは系全体の共振周波数とも関係するため、シャッター速度を早くすると解決する問題ではなく、逆にブレの像を薄くするためにシャッター速度が遅くなる設定で撮影する必要がありました。
電子シャッターのみで撮影できるミラーレスカメラでは、リモコンを使用すれば撮影時のカメラの機械的な振動は完全にゼロになります。ブレに関してはまったく気にする必要がなくなったのです。誰でも簡単に顕微鏡写真が撮れるようになりました。これは画期的なことです。
顕微鏡写真はローリングシャッター歪も関係ないので、完全電子シャッターでも撮影できる機種であれば顕微鏡カメラとして適しています。
Nikon Z50

家内の野鳥撮影カメラをZ50からZ8に変更してから、Z50を顕微鏡カメラとして使用しています。一般撮影でも優れたカメラですが、顕微鏡カメラとしても最高のパフォーマンスを発揮してくれています。
元々Fマウントのアダプターを使っていたので、FTZを挟むだけでZシステムがそのまま使用できます。三眼鏡筒の上に乗せ、液晶モニターを立てるだけで顕微鏡カメラとなります。
Z50の良いところとして、モニター像を簡単に拡大できる点があります。等倍に拡大して厳密なピント合わせができます。これは便利です。リモコンML-L7には+-のボタンもあり、モニター像の拡大縮小もリモコンでできます。まさに優れた顕微鏡専用カメラを超えたパフォーマンスです。
Z50には外部モニター出力端子もあるので、HDMI端子を持つ外部モニターを使うこともできます。厳密な調整を行う場合は重宝します。
| Amazon Link |
|---|
![]() Nikon Z50 |
![]() Nikon Z30 |
APS-Cのミラーレスカメラは顕微鏡カメラとしても優秀です。 自分はZ50を使用していますが、顕微鏡カメラに特化するのであれば、ファインダーレスのZ30も使えるでしょう。 ただし、Z30はバリアングルの液晶モニターになっているため、Z50のように同軸上に開くのではなく、横に展開される形になりますので、使い勝手が異なります。 一般撮影のカメラとしても使うのであればZ50をおすすめします。 |
機材
顕微鏡
本体
- OLYMPUS CHS-F
鏡筒
- OLYMPUS BH-TR45 3眼鏡筒
対物レンズ

- OLYMPUS PlanApo 4x, DPLAN 4x, DPLAN 10x, DPLAN 100x(oil)
- OLYMPUS PCDAch 10x(PL), PCDAch 40x(PL)
- OLYMPUS NC SPlan 40x
- OLYMPUS SPlanApo 10x, SPlanApo 20x, SPlanApo 40x, SPlanApo 60x(oil), SPlanApo 100x(oil)
- OLYMPUS SPlan FL2x
- NIKON Plan 20x
- NIKON PlanApo 10x, PlanApo 40x
- NIKON 水浸レンズ 20/0.4WI、40/0.55WI
接眼レンズ
- OLYMPUS WHK 10x
撮影レンズ
- OLYMPUS NFK2.5xLD, NFK3.3xLD, NFK5xLD, FK5x
顕微鏡アタッチメント
- Vixen (MF)Tアダプター、カメラアダプター Tリング ニコン用、FTZ
![]() Vixen (MF)Tアダプター |
![]() Vixenカメラアダプター Tリング ニコン用(N) |
![]() FTZII |
個人的に使っている撮影用アダプタです。 お使いの顕微鏡によって三眼鏡筒の仕様は異なりますので、このセットが適合するかどうかは分かりませんのでご注意ください。 20年以上前の一眼レフ時代にFマウント用として組み合わせたセットです。FTZを挟むだけでZマウントではそのまま使えました。 |
カメラボディ
- Nikon Z50
リモコン

- ML-L7
顕微鏡撮影において、リモコンは必需品です。純正品のML-L7の使用を強くおすすめします。カメラとBluetooth接続でき、Z50との接続も問題ありません。Z50を電子シャッター使用に設定しておけば、完全に無振動撮影ができるようになります。
シャッターを押すだけではなく、液晶モニターの拡大・縮小するための+-のボタン、十字キーやOKボタン、録画ボタンも備えています。拡大縮小はフォーカスポイントを中心に行われるので、カーソルキーで拡大したい位置に合わせて+ボタンを押すだけで見たい箇所が拡大されるので、大変便利です。OKボタンを押すと中央に戻ります。
構図と露出を決めた後はポイントを拡大し、フォーカスを微調整したらあとは顕微鏡もカメラも触らずに撮影できます。
逆にこのリモコンがなかったら魅力が半減しているでしょう。顕微鏡撮影や望遠鏡撮影では必需品です。
| Amazon Link |
|---|
![]() Nikon リモコン ML-L7 |
顕微鏡撮影の必需品:ML-L7 これがないと顕微鏡撮影はできないと言えるほど必須アイテムです。 |
その他
外部モニタを使う場合(HDMI変換ケーブル)
Z50のモニタ出力端子はマイクロHDMIなので、Micro HDMI(タイプD)-HDMI(タイプA)変換ケーブルが必要となります。大画面で見ることができるので、より厳密なピント合わせや、補正環の調整、露出の調整などで重宝します。

HDMIケーブルを用意すれば、Z50の液晶モニターの内容をそのまま外部の大型モニターに写すことができます。
撮影

同じようにZ50を顕微鏡カメラとして使用したい人もいるかもしれませんので、手順を書いておきます。なお、顕微鏡や三眼鏡筒、撮影レンズ、マウントアダプターなどをお持ちで、Zマウントカメラを取り付けられる状態であることが前提です。
取付
三眼鏡筒の上部にVixenTリング+Tマウント-Fマウント変換アダプタ+FTZを介してZ50 を取り付けるだけです。Fマウントまではできていたので、FTZをかませるだけで簡単に装着できます。
撮影手順
事前調整
- Z50の設定はマニュアル露出にします
- ヒストグラムを表示しておくとよいでしょう
- リモコンML-L7をZ50に登録して使える状態にしておく
- 外部モニタを持っている場合はHDMIケーブルで接続しておく
- プレパラートの標本がない部分(私はすりガラス部分をよく使います)でZ50のホワイトバランスを設定します。プリセットで決定したあとは顕微鏡の光量ダイアルを触らないようにします。光量を変更しなければ、対物レンズを変えても撮影中はZ50のホワイトバランスもそのまま使えます。光量を変更した場合はその都度ホワイトバランスは調整しなおします
撮影
- プレパラートの撮影したいターゲットを探す
- 対物レンズの倍率を決める
- 視野絞りを絞り、コンデンサの位置を調整してケーラー照明になるように調整する
- 視野絞りが視野に外接する大きさになるように調整する
- 補正環付のレンズでは補正環の調整を行う。カバーガラスの厚さやばらつきはプレパラート毎に異なるので、最高の解像度を引き出すためには必須
- 接眼レンズを抜き、対物レンズの瞳を見ながら開口絞りが瞳直径の80%程度になるように調整
- Z50の液晶モニターを見ながら適正露出となるよう、シャッター速度を調整
- モニター画像を拡大して、微動装置で厳密にピント合わせを行う
- リモコンのシャッターボタンを押す
- 標本に厚みがある場合や後に深度合成を予定している場合は、複数のピント位置で撮影する
概ねこのような流れで撮影を行っています。昔に比べて格段に楽になりました。
顕微鏡撮影の仕事は、特に高倍率の撮影依頼が多いので、ミラーレス時代になってからずいぶんと楽になりました。露出の追い込みやピント出しも楽ですが、何よりブレとの闘いが終わった恩恵が大きいと思います。安心して高倍率の撮影が可能になりました。
撮影例
あまり良い標本ではありませんが、たまたまミシシッピアカミミガメとエリマキトカゲの血液標本の撮影依頼が来ました。白血球の種類と内部の顆粒が分かるように撮影してほしいという依頼内容です。顆粒を写すとなると、必然的にある程度開口数が大きい40倍と分解能が高いApoクラスの油浸100倍が必要になります。
顆粒を撮るために開口絞りは解放で撮影しています。PlanApo100xの被写界深度は極めて浅く、塗抹標本でも血球の上下でピントがずれます。そのため、顆粒にピントを合わせると赤血球はボケるほどです。深度合成するとより良蔵が得られますが、面倒なので滅多に行いません。
ミシシッピアカミミガメ
いわゆるミドリガメの血液塗抹標本です。正常像を見たことがないので分かりませんが、好酸性(赤い)顆粒を持った好酸球様の白血球が大多数を占めています。寄生虫症か、アレルギーでもあるのでしょうか。好酸性の顆粒がつまった顆粒球ばかりで、好塩基球や好中球は見つかりませんでした。
とにかく顆粒球をたくさん撮影するよう依頼されたので、40倍と油浸100倍で撮影しました。

ACDSeeによる多焦点合成

Registax6による4枚の画像コンポジットを行い、ウェーブレット変換による顆粒の強調処理
エリマキトカゲ
ちょっと珍しい標本が届きました。一昔前に一世を風靡したエリマキトカゲの血液塗抹標本です。白血球が異常に多いので、何らかの炎症がある個体だと思います。こちらもとにかく血球の種類と、顆粒球を重点的に撮影するように依頼されました。顆粒の形や量、色も重要なので、ホワイトバランスは正確に合わせます。

| Amazon Link |
|---|
カメラ関連
![]() Nikon リモコン ML-L7 |
顕微鏡撮影の必需品:ML-L7 これがないと顕微鏡撮影はできないと言えるほど必須アイテムです。 静止画や動画のボタンの他、モニターの拡大・縮小や十字キーまで備えられているので、位置決めとフォーカシング以外、カメラや顕微鏡に触れることなく顕微鏡撮影ができます。ブレから解放されます。 |
![]() Nikon Li-ionリチャージャブルバッテリー EN-EL25 Amazon |
![]() Nikon FTZ II Amazon |
![]() 【Nizon Z50 専用】 2枚セット 超薄ガラス液晶保護フィルム Amazon |
メディア
![]() ProGrade Digital SDXC UHS-II V60 GOLD 128GB Amazon |
![]() Prograde Digital(プログレードディジタル) SD UHS-II Amazon |
![]() ProGrade Digital SDXC UHS-II V60 GOLD 512GB Amazon |
![]() Lexar SDカード 256GB Professional 1800x SDXC Amazon |
標準ズーム
![]() NIKKOR Z DX 16-50mm f/3.5-6.3 VR Amazon |
![]() NIKKOR Z 24-120mm f/4 S Amazon |
![]() NIKKOR Z 24-50mm f/4-6.3 Amazon |
![]() NIKKOR Z 24-70mm f/2.8 S Amazon |
![]() NIKKOR Z 24-70mm f/4 S Amazon |
単焦点レンズ
![]() NIKKOR Z 20mm f/1.8 S Amazon |
![]() NIKKOR Z 50mm f/1.2S Amazon |
![]() NIKKOR Z 85mm f/1.2S Amazon |
![]() NIKKOR Z MC 105mm f/2.8 VR S Amazon |
![]() NIKKOR Z 135mm f/1.8 S Plena Amazon |
望遠・超望遠レンズ
![]() NIKKOR Z DX 50-250mm f/4.5-6.3 VR Amazon |
![]() NIKKOR Z 100-400mm f/4.5-5.6 VR S Amazon |
![]() NIKKOR Z 180-600mm f/5.6-6.3 VR Amazon |
![]() NIKKOR Z 400mm f/2.8 TC VR S Amazon |
![]() NIKKOR Z 800mm f/6.3 VR S Amazon |
野鳥撮影用おすすめ超望遠レンズ(Zマウント)
Zマウント純正テレコンバーター
![]() Z TELECONVERTER TC-1.4 Amazon |
![]() Z TELECONVERTER TC-2.0 Amazon |
![]() ニコン マウントアダプターFTZII Amazon |




































